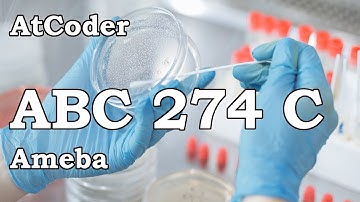
AtCoder Beginner Contest 274  C: Ameba

⬇ DOWNLOAD NOW
Jika muncul iklan pop-up, tutup lalu klik tombol kembali
Download lagu キーエンスプログラミングコンテスト2022(AtCoder Beginner Contest 274) secara gratis hanya untuk keperluan promosi. Dukung artis favorit kamu dengan membeli musik original di iTunes atau platform resmi lainnya.
 AtCoder Beginner Contest 274 F: Fishing
AtCoder Beginner Contest 274 F: Fishing キーエンスプログラミングコンテスト2024(AtCoder Beginner Contest 374)
キーエンスプログラミングコンテスト2024(AtCoder Beginner Contest 374) パナソニックグループプログラミングコンテスト2022(AtCoder Beginner Contest 273)
パナソニックグループプログラミングコンテスト2022(AtCoder Beginner Contest 273) AtCoder Beginner Contest 274 C: Ameba
AtCoder Beginner Contest 274 C: Ameba モノグサプログラミングコンテスト2024(AtCoder Beginner Contest 345)
モノグサプログラミングコンテスト2024(AtCoder Beginner Contest 345) 京セラプログラミングコンテスト2022(AtCoder Beginner Contest 271)
京セラプログラミングコンテスト2022(AtCoder Beginner Contest 271) UNICORNプログラミングコンテスト2022(AtCoder Beginner Contest 269)
UNICORNプログラミングコンテスト2022(AtCoder Beginner Contest 269) HHKBプログラミングコンテスト2022 Winter(AtCoder Beginner Contest 282)
HHKBプログラミングコンテスト2022 Winter(AtCoder Beginner Contest 282)